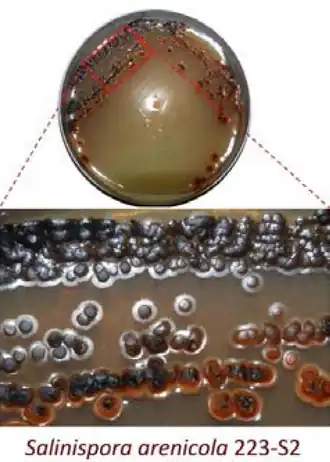

Salinispora
| Salinispora | ||||||||||||
|---|---|---|---|---|---|---|---|---|---|---|---|---|
| ||||||||||||
| Systematik | ||||||||||||
| ||||||||||||
| Wissenschaftlicher Name | ||||||||||||
| Salinispora | ||||||||||||
| Maldonado et al. 2005 |
Salinispora ist eine Gattung obligat aerober, grampositiver, nicht säurefester Bakterien, die zur Familie Micromonosporaceae gehören. Sie sind heterotroph, nicht beweglich (motil) und wachsen obligat unter Bedingungen mit hoher osmotischer / ionischer Stärke (Gradienten).[2][3][4] Salinispora ist die erste identifizierte Gattung grampositiver Bakterien, die eine hohe osmotische/
Beschreibung
Die Mitglieder von Salinispora sind gram-positive, fadenförmige Bakterien, die weit verzweigte Hyphen mit glatten Sporen bilden, die in Büscheln (Clustern) oder einzeln auftreten können.[4] Bei der Sporenbildung können sich die Sporen von kurzen sporentragenden Ausstülpungen (Sporophoren) oder (wenn festsitzend, d. h. sessil) direkt von der Basis aus verbreiten.[3][4]
Die Salinispora-Bakterien produzieren eine Reihe von Pigmenten, darunter dunkelbraune, schwarze, orangefarbene und rosafarbene.[2] Vermutlich verbringen sie einen beträchtlichen Teil der Zeit im Ruhestadium als Sporen,[6][7] wobei die Sporen im Vergleich zu den wachsenden Individuen sehr viel zahlreicher und weiter verbreitet sind. Es hat sich gezeigt, dass sie in Kultur bevorzugt in den oberen Sedimentschichten wachsen, wo auch Blüten (vgl. Algenblüten) an der Grenzschicht zwischen Sediment und Seewasser beobachtet wurden.[7]
Salinispora ist die erste beschriebene grampositive Bakteriengattung, die zum Überleben eine Umgebung mit hoher osmotischer/ionischer Stärke benötigt.[2] Dabei können die für Meerwasser üblichen Konzentrationen an Natrium-Ionen (des Salzwassers) durch solche der verwandten chemischen Elemente Kalium oder Lithium ersetzt werden.[8] Die benötigte Ionenstärke ist bei den einzelnen Salinispora-Arten unterschiedlich. Sie ist vermutlich bei allen Arten auf den Verlust des MscL-Transporters (en. Large-conductance mechanosensitive channel[9]) in den Zellmembranen zurückzuführen.[8][10]
Die Arten und Stämme von Salinispora produzieren eine große Vielfalt an Sekundärmetaboliten.[11][12] Die umfangreiche Produktion bestimmter Sekundärmetaboliten belegt deren Bedeutung für das bakterielle Überleben.[13][14] Vermutlich wurden für diese Biosynthesen verantwortlichen Gen-Cluster ursprünglich durch horizontalen Gentransfer erworben, was die hohe Sequenzähnlichkeit zwischen den Arten und Stämmen erklären könnte.[11][12] Die große Bandbreite an verschiedenen biosynthetischen Genprodukten könnte auch zur Nischendifferenzierung (Differenzierung in verschiedene ökologische Nischen) beigetragen haben. Sie kann daher zur Identifizierung spezifischer Arten und Stämme innerhalb der Gattung Salinispora verwendet werden.[13][14][15]
Vorkommen

Salinispora-Vertreter kommen häufig in tropischen und subtropischen küstennahen Meeressedimenten des Atlantiks, des Pazifiks und des Indischen Ozeans vor.[6] Sie wurden in Tiefen von bis zu 5699 m nachgewiesen. Allerdings ist unklar, ob dort um aktives Wachstum möglich ist oder ob es sich lediglich um Sporen handelt; es wurde jedoch bestätigt, dass diese Bakterien in Tiefen von bis zu 1100 m wachsen können. Da Vertreter dieser Gattung auch aus Schwämmen und Algen isoliert wurden, ist ihre Verbreitung möglicherweise nicht auf Sedimente beschränkt.[6][7]
Salinispora arenicola wurde beispielsweise aus der Weichkoralle Scleronephthya lewinsohni isoliert.[1]
Die Mehrzahl der Isolate der Art S. tropica stammen aus der Karibik, während die übrigen in allen drei Ozeanen identifiziert wurden. Die geografisch am häufigsten vorkommende Art ist S. arenicola.[16]
Etymologie
Das Präfix des Gattungsnamens kommt von neulateinisch salinus ‚Saline‘, ‚Kochsalzlösung‘ und altgriechisch σπορά spora, deutsch ‚Samen‘, ‚Spore‘ (bakteriologisch). Salinispora bedeutet also ein sporenbildendes Bakterium, das im Salzwasser lebt, was auf das marine Habitat der Organismen hinweist.[17]
Arten
Die List of Prokaryotic names with Standing in Nomenclature (LPSN) und der Taxonomy Browser des National Center for Biotechnology Information (NCBI) listen in der Gattung Salinispora derzeit (Stand 1. Juni 2022) neun Arten,[17][18] darunter die besser untersuchten S. arenicola, S. tropica und S. pacifica.[19][20] Im Jahr 2020 wurde aufgrund vergleichender Genomanalysen einer Gruppe von Stämmen, die ursprünglich alle als S. pacifica klassifiziert wurden, sechs weitere Arten von dieser abgegrenzt.[19] Aufgrund des gemeinsamen Vorkommens ist die Differenzierung dieser Arten ist wahrscheinlich eher das Ergebnis einer Nischendifferenzierung (Differenzierung in verschiedene ökologische Nischen, s. o.) als einer allopatrischen Speziation durch räumliche Trennung.[21] Trotz der hohen Sequenzähnlichkeit zwischen den Salinispora-Genomen (mehr als 99 % Sequenzidentität der 16S rRNA) wurden art- und stammbasierte Unterschiede zwischen den Biosynthese-Genclustern und den jeweiligen Produkten (Sekundärmetaboliten) festgestellt.[22][11]
Neben diesen neun offiziellen Arten listet die NCBI-Taxonomie noch mehr als 130 Artkandidaten mit vorläufigen Bezeichnungen[23] und mehr als 60 Nukleotid- bzw. 30 Protein-Sequenzen auf, die potentiell zu weiteren Arten gehören könnten.[24]
Die Genome Taxonomy Database (GTDB) synonymisiert abweichend Salinispora mit der großen Gattung Micromonospora und führt alle Spezies unter diesem Gattungsnamen (bis auf S. goodfellowii, in der GTDB nicht bekannt) – genauso wie für die nahe verwandte Gattung Verrucosispora[25] (bei der auch die LPSN- und die NCBI-Taxonomie diesen Schritt bis auf einige m. o. w. dubiose Ausnahmen vollzogen haben[26][27]).[A 1] Die GTDB ordnet dabei weitere ursprünglich S. pacifica zugeordnete Stämme den 2020 abgetrennten Spezies zu (Beispiele s. u.).
Von dieser umfangreichen Gattung Micromonospora trennt die GTDB allerdings einige andere Spezies ab in die ausgegliederten Gattungen mit den provisorischen Namen Micromonospora_E, Micromonospora_G und Micromonospora_H.[25]
Alle diese diskutierten Gattungen werden als Mitglieder der Familie Micromonosporaceae gesehen.[A 2]
Die folgende Artenliste basiert in erster Linie auf der LPSN (im Wesentlichen übereinstimmend mit der NCBI-Taxonomie), ergänzt um die abweichenden Bezeichnungen/Klassifizierungen nach der GTDB.
Gattung: Salinispora Maldonado et al. 2005 bzw. Maldonado et al. 2005 emend. Román-Ponce et al. 2020, mit Schreibvariante: „Salinospora“ Mincer et al. 2002.
Arten:
- Salinispora arenicola Maldonado et al. 2005, inklusive Salinispora sp. CNH-646 und S. sp. CNH-964 - Typus.[A 3]
GTDB: Micromonospora arenicola - Salinispora tropica Maldonado et al. 2005 bzw. Maldonado et al. 2005 emend. Nouioui et al. 2018, inkl. Salinispora sp. CNB-536
GTDB: Micromonospora tropica - Salinispora-pacifica-Gruppe[21]
- Salinispora pacifica Ahmed et al. 2014 bzw. Oh et al. 2006 oder Ahmed et al. 2014 emend. Nouioui et al. 2018, veraltet „Micromonospora lomaivitiensis“.[28][5][A 4]
GTDB: Micromonospora pacifica - Salinispora cortesiana Román-Ponce et al. 2020, inkl. Salinispora pacifica CNY202
GTDB: Micromonospora cortesiana - Salinispora fenicalii Román-Ponce et al. 2020, inkl. S. pacifica CNR942, S. p. CNT569
GTDB: Micromonospora fenicalii - Salinispora goodfellowii Román-Ponce et al. 2020, inkl. S. pacifica CNY666
GTDB: Art-Epitheton und Stamm CNY666 (inkl. Schreibvariante CNY-666) unbekannt - Salinispora mooreana Román-Ponce et al. 2020, inkl. Salinispora pacifica CNS237, S. p. CNT-150
GTDB: Micromonospora mooreana - Salinispora oceanensis Román-Ponce et al. 2020, inkl. S. pacifica CNT-138, S. p. CNT029
GTDB: Micromonospora oceanensis (inkl. Salinispora pacifica CNS860) - Salinispora vitiensis Román-Ponce et al. 2020, inkl. S. pacifica CNS801, S. p. CNT-148
GTDB: Micromonospora vitiensis (inkl. Salinispora pacifica CNS055 und Salinispora sp. H7-4)
- Salinispora pacifica Ahmed et al. 2014 bzw. Oh et al. 2006 oder Ahmed et al. 2014 emend. Nouioui et al. 2018, veraltet „Micromonospora lomaivitiensis“.[28][5][A 4]
- nicht-klassifizierte Salinispora mit vorläufigen Artnamen sowie weitere Nukleotid- und Proteinsequenzen (s. o.)[23][24]
________
Anmerkungen (Schreibvarianten der Namen der Stämme):
- CNx-nnn = CNxnnn (CNT-138 = CNT138)
- DSM nnnnn = DSM:nnnnn (DSM 44819 = DSM:44819)
- …
Pharmazeutische Bedeutung
Salinispora wurde als Modell für die Analyse von Genomsequenzdaten verwendet, um weitere Wege der Biosynthese unter Bakterien aufzudecken. Es geht dabei insbesondere auch um die Nutzbarmachung traditioneller Naturstoffe und Verfahren als Grundlage für die Erforschung und Entwicklung möglicher neuer Arzneimittel.[3] Die Betrachtung der Evolutionsgeschichte und der Vielfalt der Gattung gibt Aufschluss, auf welche Weise bei Bakterien die beobachtete chemische Vielfalt (Diversität) der verschiedenen Sekundärmetaboliten entsteht.[3][14] Viele der verschiedenen Sekundärmetaboliten von Salinispora-Spezies konnten als potenziell pharmazeutisch wertvoll identifiziert werden. Die Salinispora-Arten lassen sich anhand der Naturstoffe unterscheiden, die jede Art produziert.[15]
Sekundärmetaboliten von Salinispora arenicola
Die sekundären Stoffwechselprodukte von S. arenicola haben ein breites Spektrum an pharmazeutischen Anwendungen. Es gibt über 20 natürliche Verbindungen, die sich aus S. arenicola isolieren lassen, z. B. Arenamide,[29] Arenicolide,[30] Arenimycine[31] oder Salinisporamycin.[32] Zu den umfangreichen potenziellen Anwendungen für diese Verbindungen gehören das Unschädlichmachen von Krebszellen oder die Hemmung von Krebsvorstufen; andere Verbindungen haben antibiotische Fähigkeiten bei resistenten Bakterien, Hefen und anderen Pilzen gezeigt. Cycloaspeptide[33] können eine mögliche Medikation bei Asthma sein, da sie leicht toxisch für Lungenfibroblasten sind (menschlichen Lungenzellen, die für Entzündungen verantwortlich sind). Andere Verbindungen könnten bei der Behandlung von Schwermetallvergiftungen oder zur Senkung des Cholesterinspiegels eingesetzt werden.[15]
Sekundärmetaboliten von Salinispora pacifica
Auch wenn die Liste der identifizierten Stoffwechselprodukte von S. pacifica nicht so umfangreich ist wie bei S. arenicola, ist die mögliche pharmazeutische Nutzung dieser Substanzen interessant. Einige Verbindungen hemmen ebenfalls das Krebswachstums. Beispielsweise sind unter den Cyanosporasiden[34] potenzielle Hemmstoffe für das menschliche Kolonkarzinom.[35] Andere Metaboliten können als Antioxidantien oder Antibiotika verwendet werden.[15] Zu dieser Art gehören auch einige Metaboliten, die als Immunsuppressiva wirken können. Mycalamid A[36] wurde als potenzielles Virostatikum, Antitumormittel und sogar als mögliches HIV-Therapeutikum entdeckt, da es die Aktivierung der von HIV als Wirt bevorzugten T-Zellen hemmt.[37] Pacificanone A[38] und B[5][39] sind weitere Metaboliten mit immunsuppressiven Eigenschaften und möglichen Anwendungen bei der Behandlung von Allergien.[40]
S. pacifica produziert eine zytotoxische Familie von Sekundärmetaboliten, die Lomaiviticine.[41][42] Sie waren die ersten Verbindungen, die aus der Gattung Salinispora isoliert wurden, ihre Strukturen wurden 2001 veröffentlicht.[28] Ursprünglich wurde berichtet, dass es sich bei dem produzierenden Bakterienstamm um eine neue Micromonospora-Spezies mit dem vorgeschlagenen Namen „Micromonospora lomaivitiensis“ handelt. Weitere Gensequenzanalysen ergaben, dass es sich bei dem Stamm tatsächlich um S. pacifica handelt[5] – in der Genome Taxonomy Database (GTDB) firmiert die Spezies heute wieder als Micromonospora pacifica in dieser Gattung (s. o.).
Lomaiviticine sind aromatische Polyketide aus der Familie der Angucycline und besitzen eine Diazogruppe, die den Kinamycinen[43] ähnelt.[44] Es gibt zwei Klassen dieses Naturprodukts: Lomaiviticin A und Lomaiviticin B. Beide Klassen weisen eine starke DNA-schädigende Aktivität auf und sind nachweislich hoch zytotoxisch gegenüber menschlichen Krebszellen. Lomaiviticin A entfaltet die größere Aktivität und ist auch das häufiger vorkommende von beiden.[28]
Aufgrund ihrer besonderen molekularen Architektur und ihrer biologischen Aktivitäten sind die Lomaiviticine als Naturprodukte von großem Interesse für eine mögliche chemische Synthese. Trotz dieses großen Interesses ist die vollständige Synthese von Lomaiviticinen noch nicht gelungen (Stand 2014). Auch ist die enzymatische Chemie der Biosynthese dieser Substanzen noch nicht umfassend erforscht (Stand 2009).[45] Ausgehend von der Untersuchung ihrer charakteristischen Struktur wird angenommen, dass die Synthese dieser Produkts zur Erforschung und Entwicklung vieler neuartiger enzymatischer Reaktionen führen wird.[44][45]
Sekundärmetaboliten von Salinispora tropica
Die Zahl der aus S. tropica identifizierten und isolierten Sekundärmetaboliten ist nochmals geringer als bei den beiden oben erwähnten Arten. Die pharmazeutische und klinische Relevanz dieser Metaboliten ist jedoch wesentlich höher: Bislang sind die Salinosporamida[46] (Beispiel: Salinosporamid A[47]) aus klinischer Sicht die erfolgreichsten Sekundärmetabolite aus Salinisopora. Vertreter dieser Klasse wurden bereits in Studien am Menschen eingesetzt und haben sich als starkes Krebsmittel erwiesen.[48]
Das Genom von S. tropica wurde 2007 sequenziert.[49] Die Biosynthese von Salinosporamid A durch S. tropica erfolgt vermittels eines SalC[50] genannten Enzyms (einer Ketosynthase).[51]
S. tropica produziert darüber hinaus auch Antiprotealide,[52] ein weiteres Anti-Krebsmittel. Dieses ist möglicherweise der am stärksten wirkende Krebshemmer in der Liste der Salinispora-Sekundärmetaboliten überhaupt, denn die natürliche Verbindung ist ein sehr starkes Zytotoxin für Myelomzellen.[53]
Weblinks
- Kim Kolb: Salinispora tropica. Auf: Bioweb, University of Wisconsin
- P. R. Jensen: Salinispora tropica CNB-440T. The Society for Actinomycetes Japan.
- Salinispora tropica strain CNB-440. Auf: JGI Genome Portal, The Regents of the University of California.
- Salinispora arenicola strain DSM 44819. Auf: BacDive, DSMZ
- Christina Kucher: Potential Therapeutics Isolated from Salinispora. Auf: MicrobeWiki, Kenyon College, Department of Biology
- Salinispora. Auf: Alchetron
- Salinispora. Auf: OneZoom
- Pat Schloss: Choice 1: Pseudoalteromonas rubra and Salinispora arenicola from Patin et al. – Komplexe Interaktion zw. Pseudoalteromonas rubra (Alteromonadales) und S. arenicola, wenn beide gemeinsam auf einer Petrischale (Tweet)
- Biogeography of marine actinomycetes and the secondary metabolites they produce. Auf: Microbiology Society vom 27. August 2013
Anmerkungen
- ↑ Allerdings ordnet auch die NCBI-Taxonomie einige der früher Salinispora zugeordneten Stämme der Gattung Micromonospora zu; z. B. ordnet sie Salinispora sp. 13K206 der Spezies Micromonospora deserti Saygin et al. 2020 (DSM:107532) zu.
- ↑ In der LPSN und der NCBI Taxonomie gehört diese Familie zur Ordnung Micromonosporales, in der GTDB zu Mycobacteriales; veraltet ist wohl die Zuordnung zu den Actinomycetales. Klasse: Actinomycetia (GTDB)/
Actinobacteria (NCBI, LPSN); Phylum: Actinomycetota (LPSN)/ Actinobacteriota (GTDB). - ↑ Referenzstamm: CNH-643 = ATCC BAA-917 = DSM 44819 = JCM 13856
- ↑ Referenzstamm: CNR-114
Einzelnachweise
- ↑ a b Xanthippi P. Louka, Aimilia D. Sklirou, Géraldine Le Goff, Philippe Lopes, Eleni-Dimitra Papanagnou, Maria S. Manola, Yehuda Benayahu, Jamal Ouazzani, Ioannis P. Trougakos: Isolation of an Extract from the Soft Coral Symbiotic Microorganism Salinispora arenicola Exerting Cytoprotective and Anti-Aging Effects. In: mdpi Current issues in molecular biology. (CIMB), Band 44, Nr. 1, 2022, S. 14–30; doi:10.3390/cimb44010002, Epub 22. Dezember 2021.
- ↑ a b c d e Tracy J. Mincer, Paul R. Jensen, Christopher A. Kauffman, William Fenical: Widespread and persistent populations of a major new marine actinomycete taxon in ocean sediments. In: Applied and Environmental Microbiology. Band 68, Nr. 10, Oktober 2002, S. 5005–5011, doi:10.1128/aem.68.10.5005-5011.2002, PMID 12324350, PMC 126404 (freier Volltext), bibcode:2002ApEnM..68.5005M.
- ↑ a b c d Luis A. Maldonado, William Fenical, Paul R. Jensen, Christopher A. Kauffman, Tracy J. Mincer, Alan C. Ward, Alan T. Bull, Michael Goodfellow: Salinispora arenicola gen. nov., sp. nov. and Salinispora tropica sp. nov., obligate marine actinomycetes belonging to the family Micromonosporaceae. In: International Journal of Systematic and Evolutionary Microbiology. Band 55, Pt 5, September 2005, S. 1759–1766, doi:10.1099/ijs.0.63625-0, PMID 16166663.
- ↑ a b c Paul R. Jensen, Luis A. Maldonado, Michael Goodfellow: Salinispora. In: Bergey’s Manual of Systematics of Archaea and Bacteria. 2015, ISBN 978-1-118-96060-8, S. 1–10, doi:10.1002/9781118960608.gbm00151.
- ↑ a b c d Paul R. Jensen, Bradley S. Moore, William Fenical: The marine actinomycete genus Salinispora: a model organism for secondary metabolite discovery. In: Natural Product Reports. Band 32, Nr. 5, Mai 2015, S. 738–751, doi:10.1039/C4NP00167B, PMID 25730728, PMC 4414829 (freier Volltext). Siehe insbes. auch Salinipyrone, Pacificanone
- ↑ a b c Alejandra Prieto-Davó, Luis J. Villarreal-Gómez, Stephanie Forschner-Dancause, Alan T. Bull, James E. M. Stach, David C. Smith, Dave C. Rowley, Paul R. Jensen: Targeted search for actinomycetes from nearshore and deep-sea marine sediments. In: FEMS Microbiology Ecology. Band 84, Nr. 3, Juni 2013, S. 510–518, doi:10.1111/1574-6941.12082, PMID 23360553, PMC 3654085 (freier Volltext) – (oup.com).
- ↑ a b c Tracy J. Mincer, William Fenical, Paul R. Jensen: Culture-dependent and culture-independent diversity within the obligate marine actinomycete genus Salinispora. In: Applied and Environmental Microbiology. Band 71, Nr. 11, November 2005, S. 7019–7028, doi:10.1128/AEM.71.11.7019-7028.2005, PMID 16269737, PMC 1287694 (freier Volltext), bibcode:2005ApEnM..71.7019M.
- ↑ a b Ginger Tsueng, Kin Sing Lam: A preliminary investigation on the growth requirement for monovalent cations, divalent cations and medium ionic strength of marine actinomycete Salinispora. In: Applied Microbiology and Biotechnology. Band 86, Nr. 5, Mai 2010, S. 1525–1534, doi:10.1007/s00253-009-2424-7, PMID 20084507.
- ↑ Pfam: Family: MscL (PF01741)
- ↑ Sergio A. Bucarey, Kevin Penn, Lauren Paul, William Fenical, Paul R. Jensen: Genetic complementation of the obligate marine actinobacterium Salinispora tropica with the large mechanosensitive channel gene mscL rescues cells from osmotic downshock. In: Applied and Environmental Microbiology. Band 78, Nr. 12, Juni 2012, S. 4175–4182, doi:10.1128/aem.00577-12, PMID 22492446, PMC 3370544 (freier Volltext), bibcode:2012ApEnM..78.4175B.
- ↑ a b c Paul R. Jensen, Philip G. Williams, Dong-Chan Oh, Lisa Zeigler, William Fenical: Species-specific secondary metabolite production in marine actinomycetes of the genus Salinispora. In: Applied and Environmental Microbiology. Band 73, Nr. 4, Februar 2007, S. 1146–1152, doi:10.1128/AEM.01891-06, PMID 17158611, PMC 1828645 (freier Volltext), bibcode:2007ApEnM..73.1146J.
- ↑ a b Markus Nett, Bradley S. Moore: Exploration and engineering of biosynthetic pathways in the marine actinomycete Salinispora tropica. In: Pure and Applied Chemistry. Band 81, Nr. 6, Mai 2009, ISSN 1365-3075, S. 1075–1084, doi:10.1351/PAC-CON-08-08-08 (englisch).
- ↑ a b Utpal Bose, Amitha K. Hewavitharana, Miranda E. Vidgen, Yi Kai Ng, P. Nicholas Shaw, John A. Fuerst, Mark P. Hodson: Discovering the recondite secondary metabolome spectrum of Salinispora species: a study of inter-species diversity. In: PLOS ONE. Band 9, Nr. 3, 12. März 2014, S. e91488, doi:10.1371/journal.pone.0091488, PMID 24621594, PMC 3951395 (freier Volltext), bibcode:2014PLoSO...991488B.
- ↑ a b c Nadine Ziemert, Anna Lechner, Matthias Wietz, Natalie Millán-Aguiñaga, Krystle L. Chavarria, Paul Robert Jensen: Diversity and evolution of secondary metabolism in the marine actinomycete genus Salinispora. In: Proceedings of the National Academy of Sciences of the United States of America. Band 111, Nr. 12, März 2014, S. E1130–E1139, doi:10.1073/pnas.1324161111, PMID 24616526, PMC 3970525 (freier Volltext), bibcode:2014PNAS..111E1130Z.
- ↑ a b c d Haerin Kim, Sohee Kim, Minju Kim, Chaeyoung Lee, Inho Yang, Sang-Jip Nam: Bioactive natural products from the genus Salinospora: a review. In: Archives of Pharmacal Research. Band 43, Nr. 12, Dezember 2020, S. 1230–1258, doi:10.1007/s12272-020-01288-1, PMID 33237436.
- ↑ Kelle C. Freel, Anna Edlund, Paul R. Jensen: Microdiversity and evidence for high dispersal rates in the marine actinomycete 'Salinispora pacifica'. In: Environmental Microbiology. Band 14, Nr. 2, Februar 2012, S. 480–493, doi:10.1111/j.1462-2920.2011.02641.x, PMID 22117917, PMC 3272088 (freier Volltext).
- ↑ a b LPSN: Salinispora Maldonado et al. 2005 (Genus). Deutsche Sammlung von Mikroorganismen und Zellkulturen (DSMZ).
- ↑ NCBI Taxonomy Browser: Salinispora, Details: Salinispora Maldonado et al. 2002, …, orth. var.; Salinispora Maldonado et al. 2005 emend. Román-Ponce et al. 2020. Graphisch: Salinispora, Lifemap NCBI Version.
- ↑ a b Brenda Román-Ponce, Natalie Millán-Aguiñaga, Dulce Guillen-Matus3, Alexander B. Chase, Joape G. M. Ginigini, Katy Soapi, Klaus D. Feussner, Paul R. Jensen, Martha E. Trujillo: Six novel species of the obligate marine actinobacterium Salinispora, Salinispora cortesiana sp. nov., Salinispora fenicalii sp. nov., Salinispora goodfellowii sp. nov., Salinispora mooreana sp. nov., Salinispora oceanensis sp. nov. and Salinispora vitiensis sp. nov., and emended description of the genus Salinispora. In: International Journal of Systematic and Evolutionary Microbiology, Band 70, Nr. 8, August 2020, S. 4668–4682. microbiologyresearch.orgdoi:10.1099/ijsem.0.004330. PMID 32701422, PMC 7660244 (freier Volltext).
- ↑ Natalie Millán-Aguiñaga, Krystle L. Chavarria, Juan A. Ugalde, Anne-Catrin Letzel, Greg W. Rouse, Paul R. Jensen: Phylogenomic Insight into Salinispora (Bacteria, Actinobacteria) Species Designations. In: Scientific Reports. Band 7, Nr. 1, Juni 2017, S. 3564, doi:10.1038/s41598-017-02845-3, PMID 28620214, PMC 5472633 (freier Volltext), bibcode:2017NatSR...7.3564M.
- ↑ a b Paul R. Jensen, Chrisy Mafnas: Biogeography of the marine actinomycete Salinispora. In: Environmental Microbiology. Band 8, Nr. 11, November 2006, S. 1881–1888, doi:10.1111/j.1462-2920.2006.01093.x, PMID 17014488 (escholarship.org).
- ↑ Anelize Bauermeister, Karen Velasco-Alzate, Tiago Dias, Helena Macedo, Elthon G. Ferreira, Paula C. Jimenez, Tito M. C. Lotufo, Norberto P. Lopes, Susana P. Gaudêncio, Letícia V. Costa-Lotufo: Metabolomic Fingerprinting of Salinispora From Atlantic Oceanic Islands. In: Frontiers in Microbiology. Band 9, 11. Dezember 2018, S. 3021, doi:10.3389/fmicb.2018.03021, PMID 30619120, PMC 6297358 (freier Volltext).
- ↑ a b NCBI Taxonomy Browser: unclassified Salinispora.
- ↑ a b NCBI Taxonomy Browser: environmental samples; Nucleotide: txid306593[Organism:exp], Protein: txid306593[Organism:exp].
- ↑ a b GTDB: Micromonospora.
- ↑ LPSN: Verrucosispora Rheims et al. 1998 (Genus). Deutsche Sammlung von Mikroorganismen und Zellkulturen (DSMZ).
- ↑ NCBI Taxonomy Browser: Search for: Verrucosispora * (wild card), Verrucosispora, Details: Verrucosispora Rheims et al. 1998 emend. Xi et al. 2012 (genus). Graphisch: Verrucosispora, Lifemap NCBI Version.
- ↑ a b c Haiyin He, Wei-Dong Ding, Valerie S. Bernan, Adam D. Richardson, Chris M. Ireland, Michael Greenstein, George A. Ellestad, Guy T. Carter: Lomaiviticins A and B, potent antitumor antibiotics from Micromonospora lomaivitiensis. In: Journal of the American Chemical Society. Band 123, Nr. 22, Juni 2001, S. 5362–5363, doi:10.1021/ja010129o, PMID 11457405. Siehe insbes. Lomaiviticins A and B
- ↑ PubChem: Arenamide A, Arenamide B, Arenamide C.
- ↑
Keine Referenzen zu „Arenicolide“ gefunden. Suche nach „Arnicolide“:
PubChem: Anricolide A, Arnicolide C, Arnicolide D. - ↑
Keine Referenzen zu „Arenimycine“ gefunden. Verbindung mit ähnlichem Namen:
PubChem: Arenemycine synonym Arenaemycin E (CAS 31501-48-1) - ↑ PubChem: Salinisporamycin (Salinisporamycin A).
- ↑ PubChem: Cycloaspeptide A, Cycloaspeptide E.
- ↑ PubChem: Cyanosporaside (A, B, C, D, E, F).
- ↑ Roland D. Kersten, Amy L. Lane, Markus Nett, Taylor K. S. Richter, Brendan M. Duggan, Pieter C. Dorrestein, Bradley S. Moore: Bioactivity-guided genome mining reveals the lomaiviticin biosynthetic gene cluster in Salinispora tropica. In: ChemBioChem. Band 14, Nr. 8, Mai 2013, S. 955–962, doi:10.1002/cbic.201300147, PMID 23649992, PMC 3755882 (freier Volltext).
- ↑
Keine Referenzen zu „Mycalamid“ gefunden. Verbindung mit ähnlichem Namen wie „Mycalamid A“:
PubChem: Myxalamid A. - ↑ Kai-Xuan Yang, Dong-Sheng Ji, Haixue Zheng, Yucheng Gu, Peng-Fei Xu: Organocatalytic inverse-electron-demand Diels-Alder reaction between 5-alkenyl thiazolones and β,γ-unsaturated carbonyl compounds. In: Chemical Communications. Band 58, Nr. 26, März 2022, S. 4227–4230, doi:10.1039/D2CC00457G, PMID 35285468.
- ↑ Takayoshi Awakawa, Max Crüsemann, Jason Munguia, Nadine Ziemert, Victor Nizet, William Fenical, Bradley S. Moore: Salinipyrone and Pacificanone Are Biosynthetic By-products of the Rosamicin Polyketide Synthase. In: ChemBioChem. Band 16, Nr. 10, 30. April 2015, S. 1443–1447. doi:10.1002/cbic.201500177, siehe insbes. Salinipyrone A, Pacificanone A, Rosamicin A (Graphical Abstract).
- ↑ Kavita Tiwari, Rajinder K. Gupta: Chapter 14 - Bioactive Metabolites from Rare Actinomycetes. In: Studies in Natural Products Chemistry. Band 41, 2014, S. 419–512; doi:10.1016/B978-0-444-63294-4.00014-0. Siehe insbes. Gifhornelones B, Pacificanone A & B, Proximicin A & B, Saliniketal A.
- ↑ Dong-Chan Oh, Erin A. Gontang, Christopher A. Kauffman, Paul R. Jensen, William Fenical: Salinipyrones and pacificanones, mixed-precursor polyketides from the marine actinomycete Salinispora pacifica. In: Journal of Natural Products. Band 71, Nr. 4, April 2008, S. 570–575, doi:10.1021/np0705155, PMID 18321059, PMC 2820078 (freier Volltext).
- ↑
Christina M. Woo, Nina E. Beizer, Jeffrey E. Janso, Seth B. Herzon: Isolation of Lomaiviticins C–E, Transformation of Lomaiviticin C to Lomaiviticin A, Complete Structure Elucidation of Lomaiviticin A, and Structure–Activity Analyses. In: J. Am. Chem. Soc. Band 134, Nr. 37, 10. September 2012, S. 15285–15288; doi:10.1021/ja3074984. Siehe insbes. (−)-Lomaiviticin C, D, E (Graphical Abstract). Dazu:
- Stu Borman: A Lomaiviticin Is Scarce No More. Auf: c&en vom 24. September 2012. Siehe insbes. Lomaiviticin A, C.
- ↑ Lomaiviticin A und Lomaiviticin B. Mathews Open Access: Pharmaceutical Science.
- ↑ PubChem: Pre-Kinamycin, Kinamycin A,B,C,C',D,E,F,J,….
- ↑ a b Jeffrey E. Jansoa, Brad A. Haltli, Alessandra S. Eustáquioa, Kerry Kulowskia, Abraham J. Waldman, Li Zha, Hitomi Nakamura, Valerie S. Bernan, Haiyin He, Guy T. Cartera, Frank E. Koehn, Emily P. Balskus: Discovery of the lomaiviticin biosynthetic gene cluster in Salinispora pacifica. In: Tetrahedron. Band 70, Nr. 27–28, Juli 2014, S. 4156–4164, doi:10.1016/j.tet.2014.03.009, PMID 25045187, PMC 4101813 (freier Volltext).
- ↑ a b Srinivas Achanta: Studies toward the synthesis of lomaiviticins A and B and englerin A. Washington University, Saint Louis, Missouri 2009, OCLC 671642940. Dissertation (Ph.D.)
- ↑ PubChem: Salinosporamide A,B,C,D,E,F,G,H,I,J,K,X1–X7.
- ↑ Bradley Moore. Salinosporamide A. Final enzyme in salinosporamide A biosynthesis characterized. Quelle: Tweet von Bradley S. Moore, 21. März 2022.
- ↑ Dharminder Chauhan, Laurence Catley, Guilan Li, Klaus Podar, Teru Hideshima, Mugdha Velankar, Constantine Mitsiades, Nicolas Mitsiades, Hiroshi Yasui, Anthony Letai, Huib Ovaa, Celia Berkers, Benjamin Nicholson, Ta-Hsiang Chao, Saskia T. C. Neuteboom, Paul Richardson, Michael A. Palladino, Kenneth C. Anderson: A novel orally active proteasome inhibitor induces apoptosis in multiple myeloma cells with mechanisms distinct from Bortezomib. In: Cancer Cell. Band 8, Nr. 5, November 2005, S. 407–419, doi:10.1016/j.ccr.2005.10.013, PMID 16286248 (cell.com).
- ↑ Mario C. Aguilera: Research Highlight: Scientists Crack the Code of Potent Sea Organism. Auf: University of California - San Diego, Scripps Institution of Oceanography vom 1. Juli 2007.
- ↑ 7S2X Structure of SalC, a gamma-lactam-beta-lactone bicyclase for salinosporamide biosynthesis. Auf: RSCB Protein DataBank (PDB); doi:10.2210/pdb7S2X/pdb.
- ↑
Katherine D. Bauman, Vikram V. Shende, Percival Yang-Ting Chen, Daniela B. B. Trivella, Tobias A. M. Gulder, Sreekumar Vellalath, Daniel Romo, Bradley S. Moore: Enzymatic assembly of the salinosporamide γ-lactam-β-lactone anticancer warhead. In: Nature, Chemical Biology, Band 18, 21. März 2022, S. 538–546; doi:10.1038/s41589-022-00993-w. PMID 35314816, PMC 9058210 (freier Volltext) (ab 21. September 2022). Siehe insbes. Graphical Abstract. Dazu:
- Scientists discover how molecule becomes anticancer weapon. EurekAlert!, 21. März 2022. Quelle: University of California - San Diego
- Scientists Discover How Molecule From Deep-Sea Microbe Becomes Potent Anticancer Weapon. Auf: SciTechDaily vom 21. März 2022. Quelle: University of California - San Diego
- Synthesis of Bacterium’s Anticancer Warhead Described. Auf: GeneticEngineering & Biotechnology News vom 22. März 2022.
- ↑ PubChem: Antiprotealide.
- ↑ Rama Rao Manam, Venkat R. Macherla, Ginger Tsueng, Chris W. Dring, Jeffrey Weiss, Saskia T. C. Neuteboom, Kin S. Lam, Barbara C. Potts: Antiprotealide is a natural product. In: Journal of Natural Products. Band 72, Nr. 2, Februar 2009, S. 295–297, doi:10.1021/np800578e, PMID 19133779.